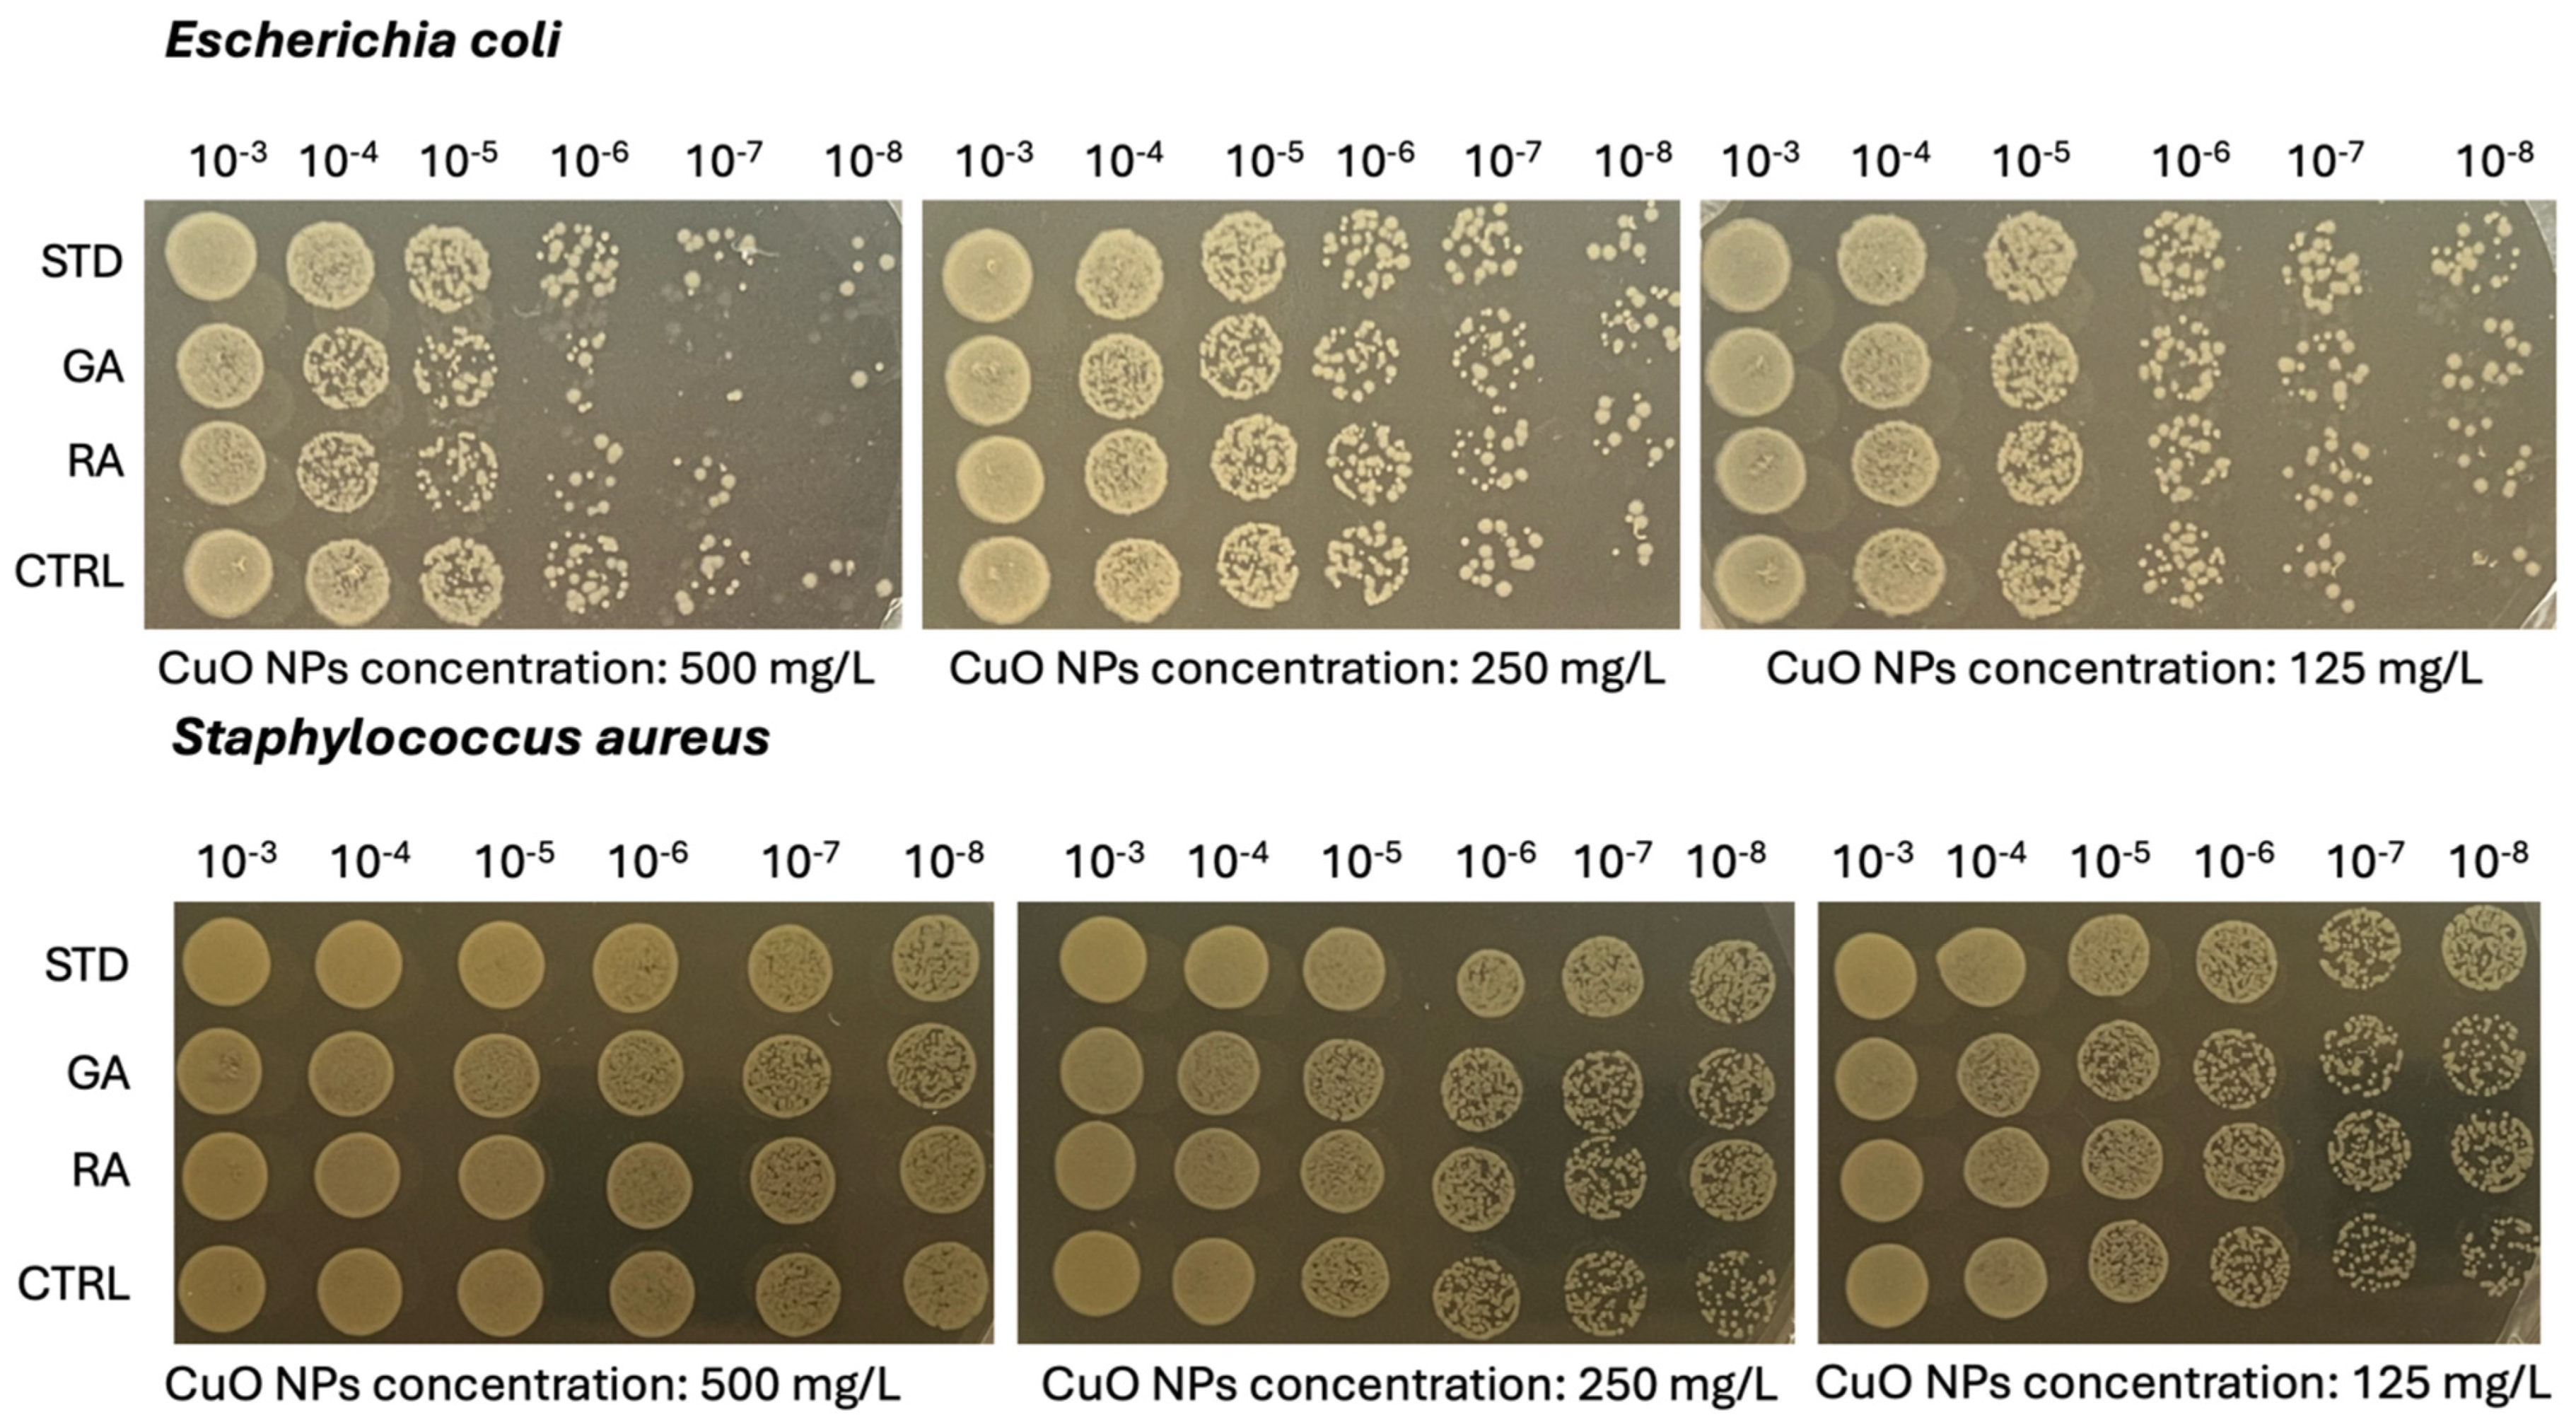
Nanomaterials 14 01157 g007b

Green Synthesis of CuO Nanoparticles from Macroalgae Ulva lactuca and Gracilaria verrucosa
Abstract
1. Introduction
2. Results and Discussion
2.1. Green Synthesis of CuO Nanoparticles from Macroalgae
2.2. XRD Nanoparticle Characterization
2.3. TEM/EDX
2.4. FTIR Analyses
2.5. Reactive Oxygen Species (ROS) Scavenging Capacity
2.6. Microbiological Analysis on Copper Oxide (CuO) NPs
3. Materials and Methods
3.1. Macroalgae Biomass Collection and Extraction Process
3.2. NP Synthesis
3.3. Nanoparticle Characterization
3.3.1. XRD
3.3.2. HRTEM/EDX
3.3.3. Zeta Potential, Particle Size and Dissolution
3.3.4. FTIR
3.3.5. DPPH Assay for Free Radical Scavenging Capacity
3.3.6. Microbiological Analysis on Copper Oxide (CuO) Nanoparticles (NPs)
3.3.7. Flow Cytometry on Yeasts
4. Conclusions
Supplementary Materials
Author Contributions
Funding
Data Availability Statement
Acknowledgments
Conflicts of Interest
References
- Gnanajobitha, G. Fruit-mediated synthesis of silver nanoparticles using Vitis vinifera and evaluation of their antimicrobial efficacy. J. Nanostruct. Chem. 2013, 3, 67. [Google Scholar] [CrossRef]
- Suresh, A.K.; Pelletier, D.A.; Wang, W.; Broich, M.L.; Moon, J.W.; Gu, B.; Allison, D.P.; Joy, D.C.; Phelps, T.J.; Doktycz, M.J. Biofabrication of discrete spherical gold nanoparticles using the metal-reducing bacterium Shewanella oneidensis. Acta Biomater. 2011, 7, 2148–2152. [Google Scholar] [CrossRef]
- Kumar, D.A.; Palanichamy, V.; Roopan, S.M. Green synthesis of silver nanoparticles using Alternanthera dentata leaf extract at room temperature and their antimicrobial activity. Spectrochim. Acta Part. A Mol. Biomol. Spectrosc. 2014, 127, 168–171. [Google Scholar] [CrossRef] [PubMed]
- Mariselvam, R.; Ranjitsingh, A.J.A.; Usha Raja Nanthini, A.; Kalirajan, K.; Padmalatha, C.; Mosae Selvakumar, P. Green synthesis of silver nanoparticles from the extract of the inflorescence of Cocos nucifera (Family: Arecaceae) for enhanced antibacterial activity. Spectrochim. Acta Part. A Mol. Biomol. Spectrosc. 2014, 129, 537–541. [Google Scholar] [CrossRef] [PubMed]
- Ortiz de Zárate, D.; García-Meca, C.; Pinilla-Cienfuegos, E.; Ayúcar, J.A.; Griol, A.; Bellières, L.; Hontañón, E.; Kruis, F.E.; Martí, J. Green and Sustainable Manufacture of Ultrapure Engineered Nanomaterials. Nanomaterials 2020, 10, 466. [Google Scholar] [CrossRef] [PubMed]
- Carenco, S.; Portehault, D.; Boissière, C.; Mézailles, N.; Sanchez, C. 25th Anniversary Article: Exploring Nanoscaled Matter from Speciation to Phase Diagrams: Metal Phosphide Nanoparticles as a Case of Study. Adv. Mater. 2014, 26, 371–390. [Google Scholar] [CrossRef]
- Jin, R. The impacts of nanotechnology on catalysis by precious metal nanoparticles. Nanotechnol. Rev. 2012, 1, 31–56. [Google Scholar] [CrossRef]
- Pearce, A.K.; Wilks, T.R.; Arno, M.C.; O’reilly, R.K. Synthesis and applications of anisotropic nanoparticles with precisely defined dimensions. Nat. Rev. Chem. 2021, 5, 21–45. [Google Scholar] [CrossRef]
- Mourdikoudis, S.; Pallares, R.M.; Thanh, N.T.K. Characterization techniques for nanoparticles: Comparison and complementarity upon studying nanoparticle properties. Nanoscale 2018, 10, 12871. [Google Scholar] [CrossRef]
- Zhao, J.; Stenzel, M.H. Entry of nanoparticles into cells: The importance of nanoparticle properties. Polym. Chem. 2018, 9, 259–272. [Google Scholar] [CrossRef]
- El-Seedi, H.R.; El-Shabasy, R.M.; Khalifa, S.A.M.; Saeed, A.; Shah, A.; Shah, R.; Iftikhar, F.J.; Abdel-Daim, M.M.; Omri, A.; Hajrahand, N.H.; et al. Metal nanoparticles fabricated by green chemistry using natural extracts: Biosynthesis, mechanisms, and applications. RSC Adv. 2019, 9, 24539. [Google Scholar] [CrossRef] [PubMed]
- Singh, A.; Jain, D.; Upadhyay, M.K.; Khandelwal, N.; Verma, H.N. Green synthesis of silver nanoparticles using Argemone mexicana leaf extract and evaluation of their antimicrobial activities. Dig. J. Nanomater. Biostructures 2010, 5, 483–489. [Google Scholar]
- Khan, I.; Saeed, K.; Khan, I. Nanoparticles: Properties, applications and toxicities. Arab. J. Chem. 2019, 12, 908–931. [Google Scholar] [CrossRef]
- Nath, D.; Banerjee, P. Green nanotechnology—A new hope for medical biology. Toxicol. Pharmacol. 2013, 36, 997–1014. [Google Scholar] [CrossRef]
- Abid, N.; Khan, A.M.; Shujait, S.; Chaudhary, K.; Ikram, M.; Imran, M.; Haider, J.; Khan, M.; Khan, Q.; Maqbool, M. Synthesis of nanomaterials using various top-down and bottom-up approaches, influencing factors, advantages, and disadvantages: A review. Adv. Colloid. Interface 2022, 18, 156–166. [Google Scholar] [CrossRef] [PubMed]
- Thakkar, K.N.; Mhatre, S.S.; Parikh, R.Y. Biological synthesis of metallic nanoparticles. Nanomed. Nanotechnol. Biol. Med. 2010, 6, 257–262. [Google Scholar] [CrossRef] [PubMed]
- Türk, M.; Erkey, C. Synthesis of supported nanoparticles in supercritical fluids by supercritical fluid reactive deposition: Current state, further perspectives and needs. J. Supercrit. Fluids 2018, 134, 176–183. [Google Scholar] [CrossRef]
- Sangeetha, N.; Saravanan, K. Biogenic silver nanoparticles using marine seaweed (Ulva lactuca) and evaluation of its antibacterial activity. J. Nanosci. Nanotechnol. 2014, 2, 99–102. [Google Scholar]
- Marmiroli, N.; White, J.C.; Song, J. (Eds.) Exposure to Engineered Nanomaterials in the Environment; Micro&Nano Technologies Series; Elsevier: Amsterdam, The Netherlands, 2019. [Google Scholar]
- Rajeshkumar, S.; Nandhini, N.T.; Manjunath, K.; Sivaperumal, P.; Prasad, G.K.; Alotaibi, S.S.; Roopan, S.M. Environment friendly synthesis copper oxide nanoparticles and its antioxidant, antibacterial activities using Seaweed (Sargassum longifolium) extract. J. Mol. Struct. 2021, 1242, 130724. [Google Scholar] [CrossRef]
- Zulfiqar, H.; Zafar, A.; Rasheed, M.N.; Ali, Z.; Mehmood, K.; Mazher, A.; Hasan, M.; Mahmood, N. Synthesis of silver nanoparticles using Fagonia cretica and their antimicrobial activities. Nanoscale Adv. 2018, 4, 1707–1713. [Google Scholar] [CrossRef]
- Ficko-Blean, E.; Hervé, C.; Michel, G. Sweet and sour sugars from the sea: The biosynthesis and remodeling of sulfated cell wall polysaccharides from marine macroalgae. Perspect. Phycol. 2015, 2, 251–264. [Google Scholar] [CrossRef]
- Hu, J.; Wang, Z.; Li, J. Gold nanoparticles with special shapes: Controlled synthesis, surface-enhanced Raman scattering, and the application in biodetection. Sensors 2007, 7, 3299–3311. [Google Scholar] [CrossRef] [PubMed]
- Barciela, P.; Carpena, M.; Li, N.Y.; Liu, C.; Jafari, S.M.; Simal-Gandara, J.; Prieto, M.A. Macroalgae as biofactories of metal nanoparticles; biosynthesis and food applications. Adv. Colloid. Interface Sci. 2023, 311, 102829. [Google Scholar] [CrossRef]
- Ray, B.; Lahaye, M. Cell-wall polysaccharides from the marine green alga Ulva “rigida” (Ulvales, Chlorophyta). Chemical structure of ulvan. Carbohydr. Res. 1995, 274, 251–261. [Google Scholar] [CrossRef]
- Kloareg, B.; Badis, Y.; Cock, J.M.; Michel, G. Role and Evolution of the Extracellular Matrix in the Acquisition of Complex Multicellularity in Eukaryotes: A Macroalgal Perspective. Genes 2021, 12, 1059–1167. [Google Scholar] [CrossRef]
- Castro, L.; Blázquez, M.L.; Muñoz, J.A.; González, F.; Ballester, A. Biological synthesis of metallic nanoparticles using algae. IET Nanobiotechnol. 2013, 7, 109–116. [Google Scholar] [CrossRef]
- Khalil, I.; Yehye, W.A.; Etxeberria, A.E.; Alhadi, A.A.; Dezfooli, S.M.; Julkapli, N.B.M.; Basirun, W.J.; Seyfoddin, A. Nanoantioxidants: Recent Trends in Antioxidant Delivery Applications. Antioxidants 2020, 9, 24. [Google Scholar] [CrossRef] [PubMed]
- Singaravely, G.; Arockiamary, J.; Kumar, V.G.; Govindaraju, K. A novel extracellular synthesis of monodisperse gold nanoparticles using marine alga, Sargassum wightii Greville. Colloids Surf. B Biointerfaces 2007, 57, 97–101. [Google Scholar] [CrossRef] [PubMed]
- World Health Organitation. Antimicrobial Resistance; WHO: Geneva, Switzerland, 2021. [Google Scholar]
- EClinica Medicine. Antimicrobial Resistance: A Top Ten Global Public Health Threat. eClinical Med. 2021, 41, 101221. [Google Scholar] [CrossRef] [PubMed]
- Vestby, L.K.; Grønseth, T.; Simm, R.; Nesse, L.L. Bacterial Biofilm and its Role in the Pathogenesis of Disease. Antibiotics 2020, 9, 59. [Google Scholar] [CrossRef]
- World Health Organization. Fungal Priority Pathogens List to Guide Research, Development and Public Health Action; WHO: Geneva, Switzerland, 2022. [Google Scholar]
- De Oliveira, D.M.P.; Forde, B.M.; Kidd, T.J.; Harris, P.N.A.; Schembri, M.A.; Beatson, S.A.; Paterson, D.L.; Walker, M.J. Antimicrobial Resistance in ESKAPE Pathogens. Clin. Microbiol. Rev. 2020, 33, e00181-19. [Google Scholar] [CrossRef] [PubMed]
- Mussin, J.; Giusiano, G. Biogenic silver nanoparticles as antifungal agents. Front. Chem. 2022, 10, 1023542. [Google Scholar] [CrossRef] [PubMed]
- Pereira, A.M.; Costa, A.D.; Dias, S.C.; Casal, M.; Machado, R. Production and Purification of Two Bioactive Antimicrobial Peptides Using a Two-Step Approach Involving an Elastin-Like Fusion Tag. Pharmaceuticals 2021, 14, 956. [Google Scholar] [CrossRef] [PubMed]
- Mantri, V.A.; Kavale, M.G.; Kazi, M.A. Seaweed Biodiversity of India: Reviewing Current Knowledge to Identify Gaps, Challenges, and Opportunities. Diversity 2019, 12, 13. [Google Scholar] [CrossRef]
- De Almeida, C.L.F.; Falcão, H.d.S.; Lima, G.R.d.M.; Montenegro, C.d.A.; Lira, N.S.; de Athayde-Filho, P.F.; Rodrigues, L.C.; De Souza, M.d.F.V.; Barbosa-Filho, J.M.; Batista, L.M. Bioactivities from Marine Algae of the Genus Gracilaria. Int. J. Mol. Sci. 2011, 12, 4550–4573. [Google Scholar] [CrossRef] [PubMed]
- Chellapandian, C.; Ramkumar, B.; Puja, P.; Shanmuganathan, R.; Pugazhendhi, A.; Kumar, P. Gold nanoparticles using red seaweed Gracilaria verrucosa: Green synthesis, characterization and biocompatibility studies. Process. Biochem. 2019, 80, 58–63. [Google Scholar] [CrossRef]
- Pappou, S.; Dardavila, M.M.; Savvidou, M.G.; Louli, V.; Magoulas, K.; Voutsas, E. Extraction of Bioactive Compounds from Ulva lactuca. Appl. Sci. 2022, 12, 2117. [Google Scholar] [CrossRef]
- Zaldívar, J.; Cattaneo, E.; Plus, M.; Murray, C.; Giordani, G.; Viaroli, P. Long-term simulation of main biogeochemical events in a coastal lagoon: Sacca Di Goro (Northern Adriatic Coast, Italy). Cont. Shelf Res. 2003, 23, 1847–1875. [Google Scholar] [CrossRef]
- Viaroli, P.; Azzoni, R.; Bartoli, M.; Giordani, G.; Tajé, L. Evolution of the trophic conditions and dystrophic outbreaks in the Sacca di Goro lagoon. In Northern Adriatic Sea; Faranda, F.M., Guglielmo, L., Spezie, G., Eds.; Structure and Processes in the Mediterranean Ecosystems; Springer: Berlin/Heidelberg, Germany; New York, NY, USA, 2001; p. 443. [Google Scholar]
- Makarov, M.V.; Ryzhik, I.V.; Voskoboinikov, G.M. The Effect of Fucus vesiculosus L. (Phaeophyceae) Depth of Vegetation in the Barents Sea (Russia) on Its Morphophysiological Parameters. Int. J. Algae 2013, 15, 77–90. [Google Scholar] [CrossRef]
- Marmiroli, M.; Pagano, L.; Rossi, R.; De La Torre-Roche, R.; Lepore, G.O.; Ruotolo, R.; Gariani, G.; Bonanni, V.; Pollastri, S.; Puri, A.; et al. Copper Oxide nanomaterial fate in plant tissue: Nanoscale impacts on reproductive tissues. Environ. Sci. Technol. 2021, 55, 10769–10783. [Google Scholar] [CrossRef]
- Sivakumar, S.; Jin, D.X.; Rathod, R.; Ross, J.; Cantley, L.C.; Scaltriti, M.; Chen, J.W.; Hutchinson, K.E.; Wilson, T.R.; Sokol, E.S.; et al. Genetic Heterogeneity and Tissue-specific Patterns of Tumors with Multiple PIK3CA Mutations. Clin. Cancer Res. 2023, 29, 1125–1136. [Google Scholar] [CrossRef] [PubMed]
- Rajeshkumar, S.; Aboelfetoh, E.F.; Balusamy, S.R.; Ali, D.; Almarzoug, M.H.A.; Tesfaye, J.L.; Krishnaraj, R. Anticancer, Enhanced Antibacterial, and Free Radical Scavenging Potential of Fucoidan-(Fucus vesiculosus Source) Mediated Silver Nanoparticles. Oxid. Med. Cell Longev. 2021, 2021, 8511576. [Google Scholar] [CrossRef]
- Coates, J. Interpretation of Infrared Spectra, A Practical Approach. In Encyclopedia of Analytical Chemistry; Meyers, R.A., Ed.; John Wiley & Sons Ltd.: Chichester, UK, 2000; pp. 10815–10837. [Google Scholar]
- Abidi, N. FTIR Microspectroscopy Selected Emerging Applications; Springer Nature Switzerland: Cham, Switzerland, 2021; ISBN 978-3-030-84424-0. [Google Scholar]
- Kasemets, K.; Ivask, A.; Dubourguier, H.C.; Kahru, A. Toxicity of nanoparticles of ZnO, CuO and TiO2 to yeast Saccharomyces cerevisiae. Toxicol. Vitr. 2009, 23, 1116–1122. [Google Scholar] [CrossRef]
- Pagano, L.; Maestri, E.; Caldara, M.; White, J.C.; Marmiroli, N.; Marmiroli, M. Engineered nanomaterial activity at the organelle level: Impacts on the chloroplasts and mitochondria. ACS Sustain. Chem. Eng. 2018, 6, 12562–12579. [Google Scholar] [CrossRef]
- Zhang, Y.; Wang, L.; Xu, X.; Li, F.; Wu, Q. Combined systems of different antibiotics with nano-CuO against Escherichia coli and the mechanisms involved. Nanomedicine 2018, 13, 339–351. [Google Scholar] [CrossRef] [PubMed]
- Dominguez, H.; Loret, E.P. Ulva lactuca, A Source of Troubles and Potential Riches. Mar. Drugs 2019, 17, 357. [Google Scholar] [CrossRef]
- Fredericq, S.; Hommersand, M.H. Proposal of the Gracilariales ord. nov. (Rhodophyta) based on an analysis of the reproductive development of Gracilaria verrucosa. J. Phycol. 1989, 25, 213–227,257. [Google Scholar] [CrossRef]
- Fatima, R.; Priya, M.; Indurthi, L.; Radhakrishnan, V.; Sudhakaran, R. Biosynthesis of silver nanoparticles using red algae Portieria hornemannii and its antibacterial activity against fish pathogens. Microb. Pathog. 2020, 138, 103780. [Google Scholar] [CrossRef]
- Jayarambabu, N.; Akshaykranth, A.; Venkatappa Rao, T.; Venkateswara Rao, K.; Rakesh Kumar, R. Green synthesis of Cu nanoparticles using Curcuma longa extract and their application in antimicrobial activity. Mater. Lett. 2020, 259, 126813. [Google Scholar] [CrossRef]
- Pagano, L.; Marmiroli, M.; Villani, M.; Magnani, J.; Rossi, R.; Zappettini, A.; White, J.C.; Marmiroli, N. Engineered nanomaterial exposure affects organelle genetic material replication in Arabidopsis thaliana. ACS Nano 2022, 16, 2249–2260. [Google Scholar] [CrossRef]

| Candida albicans | ||||||||||||
| NP Concentration (mg L−1) | ||||||||||||
| 500 | 250 | 125 | 62.5 | 31.3 | 15.6 | 7.8 | 3.9 | 2.0 | 1.0 | 0.5 | CTRL | |
| STD NPs | 1.098 | 1.233 | 1.31 | 1.342 | 1.349 | 1.335 | 1.333 | 1.361 | 1.364 | 1.377 | 1.372 | 1.341 |
| GA NPs | 1.092 | 1.259 | 1.326 | 1.363 | 1.362 | 1.367 | 1.386 | 1.393 | 1.382 | 1.383 | 1.391 | 1.343 |
| RA NPs | 1.11 | 1.304 | 1.363 | 1.383 | 1.374 | 1.398 | 1.407 | 1.387 | 1.399 | 1.393 | 1.396 | 1.407 |
| Saccharomyces cerevisiae | ||||||||||||
| NP Concentration (mg L−1) | ||||||||||||
| 500 | 250 | 125 | 62.5 | 31.3 | 15.6 | 7.8 | 3.9 | 2.0 | 1.0 | 0.5 | CTRL | |
| STD NPs | 0.915 | 1.021 | 1.111 | 1.13 | 1.218 | 1.141 | 1.246 | 1.249 | 1.248 | 1.249 | 1.206 | 1.114 |
| GA NPs | 0.863 | 0.982 | 1.079 | 1.177 | 1.158 | 1.191 | 1.226 | 1.253 | 1.235 | 1.283 | 1.314 | 1.231 |
| RA NPs | 0.831 | 1.013 | 1.129 | 1.127 | 1.2 | 1.233 | 1.248 | 1.304 | 1.304 | 1.334 | 1.375 | 1.354 |
| Bacillus subtilis | ||||||||||||
| NP Concentration (mg L−1) | ||||||||||||
| 500 | 250 | 125 | 62.5 | 31.3 | 15.6 | 7.8 | 3.9 | 2.0 | 1.0 | 0.5 | CTRL | |
| STD NPs | 0.05 | 0.05 | 0.05 | 0.11 | 0.634 | 0.921 | 0.965 | 0.996 | 0.965 | 1.025 | 0.995 | 0.997 |
| GA NPs | 0.566 | 0.856 | 0.921 | 0.985 | 1.005 | 1.025 | 1.008 | 1.013 | 1.007 | 0.966 | 0.975 | 0.999 |
| RA NPs | 0.613 | 0.811 | 0.892 | 0.964 | 0.984 | 1.014 | 1.037 | 0.998 | 1.029 | 1.028 | 1.022 | 1.053 |
| Staphylococcus aureus | ||||||||||||
| NP Concentration (mg L−1) | ||||||||||||
| 500 | 250 | 125 | 62.5 | 31.3 | 15.6 | 7.8 | 3.9 | 2.0 | 1.0 | 0.5 | CTRL | |
| STD NPs | 0.619 | 0.549 | 0.618 | 0.596 | 0.536 | 0.561 | 0.563 | 0.529 | 0.55 | 0.588 | 0.6 | 0.675 |
| GA NPs | 0.481 | 0.473 | 0.555 | 0.523 | 0.528 | 0.542 | 0.534 | 0.523 | 0.54 | 0.552 | 0.538 | 0.666 |
| RA NPs | 0.455 | 0.371 | 0.542 | 0.452 | 0.531 | 0.607 | 0.506 | 0.549 | 0.465 | 0.58 | 0.52 | 0.69 |
| Growth Inhibition (OD600 = 0.05) | |||
| NP concentrations (mg L−1) | |||
| STD NPs | GA NPs | RA NPs | |
| Candida albicans | nd | nd | nd |
| Saccharomyces cerevisiae | nd | nd | nd |
| Bacillus subtilis | 125 | nd | nd |
| Escherichia coli | nd | nd | 500 |
| Staphylococcus aureus | nd | nd | nd |
| 50% growth reduction compared to the untreated control | |||
| NP concentrations (mg L−1) | |||
| STD NPs | GA NPs | RA NPs | |
| Candida albicans | nd | nd | nd |
| Saccharomyces cerevisiae | nd | nd | nd |
| Bacillus subtilis | 62.5 | nd | nd |
| Escherichia coli | nd | nd | 250 |
| Staphylococcus aureus | nd | nd | nd |
| 25% growth reduction compared to the untreated control | |||
| NP concentrations (mg L−1) | |||
| STD NPs | GA NPs | RA NPs | |
| Candida albicans | nd | nd | nd |
| Saccharomyces cerevisiae | nd | 500 | 250 |
| Bacillus subtilis | 31.25 | 500 | 500 |
| Escherichia coli | nd | 500 | 125 |
| Staphylococcus aureus | nd | 500 | 250 |
Disclaimer/Publisher’s Note: The statements, opinions and data contained in all publications are solely those of the individual author(s) and contributor(s) and not of MDPI and/or the editor(s). MDPI and/or the editor(s) disclaim responsibility for any injury to people or property resulting from any ideas, methods, instructions or products referred to in the content. |
© 2024 by the authors. Licensee MDPI, Basel, Switzerland. This article is an open access article distributed under the terms and conditions of the Creative Commons Attribution (CC BY) license (https://creativecommons.org/licenses/by/4.0/).
Share and Cite
Marmiroli, M.; Villani, M.; Scarponi, P.; Carlo, S.; Pagano, L.; Sinisi, V.; Lazzarini, L.; Pavlicevic, M.; Marmiroli, N. Green Synthesis of CuO Nanoparticles from Macroalgae Ulva lactuca and Gracilaria verrucosa. Nanomaterials 2024, 14, 1157. https://doi.org/10.3390/nano14131157
Marmiroli M, Villani M, Scarponi P, Carlo S, Pagano L, Sinisi V, Lazzarini L, Pavlicevic M, Marmiroli N. Green Synthesis of CuO Nanoparticles from Macroalgae Ulva lactuca and Gracilaria verrucosa. Nanomaterials. 2024; 14(13):1157. https://doi.org/10.3390/nano14131157
Chicago/Turabian StyleMarmiroli, Marta, Marco Villani, Paolina Scarponi, Silvia Carlo, Luca Pagano, Valentina Sinisi, Laura Lazzarini, Milica Pavlicevic, and Nelson Marmiroli. 2024. "Green Synthesis of CuO Nanoparticles from Macroalgae Ulva lactuca and Gracilaria verrucosa" Nanomaterials 14, no. 13: 1157. https://doi.org/10.3390/nano14131157
APA StyleMarmiroli, M., Villani, M., Scarponi, P., Carlo, S., Pagano, L., Sinisi, V., Lazzarini, L., Pavlicevic, M., & Marmiroli, N. (2024). Green Synthesis of CuO Nanoparticles from Macroalgae Ulva lactuca and Gracilaria verrucosa. Nanomaterials, 14(13), 1157. https://doi.org/10.3390/nano14131157

